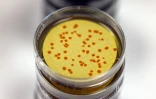
laboratoire de microlab
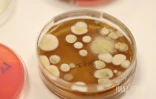
laboratoire de microlab

Ce jeudi 18 juillet 2024, l'ARS en partenariat avec Microlab ont présenté les dernières modernisations du site eaudurobinet.re. Bien que l'eau de La Réunion soit en majorité propre à la consommation, certaines conditions météorologiques peuvent altérer sa potabilité. L'objectif de cette modernisation est donc montrer de manière transparente à la population la qualité de l'eau qui coulent de leur robinet et ce en tout temps (Photo : sly/www.imazpress.com)
"Notre objectif premier est d’être transparent quant à la qualité de l’eau que les Réunionnais consomment", déclare Gérard Cotellon directeur général de l’agence régionale de santé (ARS).
Avec la création du site eaudurobinet.re en 2016, une remise à neuf du site permet désormais de mieux informer sur la qualité de l’eau qui sort de leurs robinets. "Désormais ils peuvent accéder aux résultats d’analyses des prélèvements d’eaux réalisés sur l’ensemble des secteurs de l’île bien que cela puisse mettre certaines communes dans une situation délicate", affirme le directeur de l’ARS.
"Ce partenariat avec Microlab permet de récolter des données précises et totalement indépendantes de celles récoltées par les autres filières s'occupant de la redistribution de l'eau dans l'île", explique Gérard Cotellon. Il ajoute : "ce site offre une fiche détaillée des prélèvements selon son secteur". Regardez
- Une remise à neuf du site -
Sur ce site, de nombreuses nouveautés ont été ajoutées lors de la modernisation de 2024 :
• Une information directe sur la qualité de l’eau à son robinet
En entrant son adresse dans la barre de recherche en page d’accueil, chacun pourra désormais accéder aux résultats des dernières analyses effectuées par l’ARS sur le réseau d’eau qui le dessert.
• Les dernières actualités
Les Réunionnais peuvent accéder aux dernières informations concernant l’eau potable sur l’île : réseau de potabilisation, qualité de l’eau par secteur, résultats d’analyse.
• Des conseils pratiques
Dans cette rubrique : des informations et conseils en cas de situations particulières ou exceptionnelles (cyclone, fortes pluies ...).
• Un accès sur téléphone
Pour un aspect pratique, cette nouvelle version du site internet est adapté à la consultation depuis un téléphone portable.
• De meilleures informations sur la surveillance, le contrôle de la qualité de l’eau potable et la préservation de l’eau à La Réunion,
• La consultation en ligne du bilan Infofacture sur la qualité de l’eau du robinet
Cette fiche d’information annuelle est rédigée par l’ARS et transmise par chaque gestionnaire du réseau de l’eau lors de l’envoi de la facture aux abonnés. Il reprend les éléments du contrôle sanitaire (microbiologie, nitrates, pesticides, etc), avec des recommandations.
- Une eau de bonne qualité –
« L’eau à La Réunion est de manière générale d’excellente qualité qui peut, en cas de phénomène météorologique, se dégrader », rappelle Jérémy Vivancos co-gérant et directeur scientifique de Microlab.
Ces épisodes pluvieux ne sont d’ailleurs pas rares sur l’île : c’est pour cela que les préleveurs vont récolter des échantillons d’eau. Sur un an, c’est plus de 3.500 prélèvements qui sont réalisés sur différents secteurs, à différents captages et à des moments inopinés.
Il faut ensuite procéder aux analyses : « Le but est de quantifier plus de 150 paramètres dont les deux premiers sont analysés sur place. Il s’agit de la quantité de chlore ainsi que le PH », détaille le directeur scientifique.
Ces échantillons sont ensuite rapatriés au laboratoire pour les soumettre à quatre grandes familles d’analyses :
- L’analyse microbiologique : permettant de chercher les agents pathogènes susceptibles de causer de possibles maladies,
- L’analyse chimique minérale : détectant la possible présence de fer ou d’aluminium dans l’eau,
- L’analyse chimique organique : permet de repérer les polluants dans l’eau comme les pesticides qui représentent à elles seules 151 molécules à analyser,
- L’analyse radiologique : qui va déceler si l’eau contient des éléments radioactifs.
Des analyses qui sont réalisées autant sur eaux destinées à la consommation humaine (EDCH), tous comme les eaux récréatives (rivières, piscines, plages). Regardez
- Pouvoir agir sur la qualité –
À La Réunion, c’est un total de 158 unités de distribution, redispatchés par plusieurs exploitants tels que Runéo, la Cise, la Cirest et bien d’autres, qui alimentent les populations en eau. « C’est pour cela que s’il y a des défaillances dans ces résultats, il faut mener des actions correctives », affirme Jérôme Benoit responsable de la cellule eau potable à l’ARS.
Pour cela il existe des usines de potabilisation mise en place ou à venir sur différents endroit de l'île :
- Les usines de Saint-Leu et Petite-Île sont déjà actives,
- Les usines du Tampon et de Saint-Pierre ont subit des travaux de raccordement,
- Les usines de l'Etang-Salé et de Saint-Louis seront opérationnels dans le courant 2025.
« Si l’information sur une eau impropre à la consommation est passée, la population attend par la suite une information claire et surtout actualisée », poursuit le responsable de la cellule eau potable. Il renchérit : « Cette plateforme vient en réponse à ce besoin d’être plus réactif face à la pression sur les ressources en eau de plus en plus utilisés par la population ». Regardez
Pour le moment, le site n’offre pas encore la possibilité d’être géolocalisée, mais cette fonctionnalité fait déjà son petit bout de chemin chez les têtes pensantes de l’ARS.
cn/www.imazpress.com/[email protected]

Site non accessible
Ca commence bien :-) ! En essayant eaudurobinet.re : '503 Service Unavailable
No server is available to handle this request' donc pour la geolocalisation..il faudra sans doute attendre, effectivement :-) !
Il y a bien longtemps que l'eau potable n'existe plus !
J'en ai fait l'expèrience.